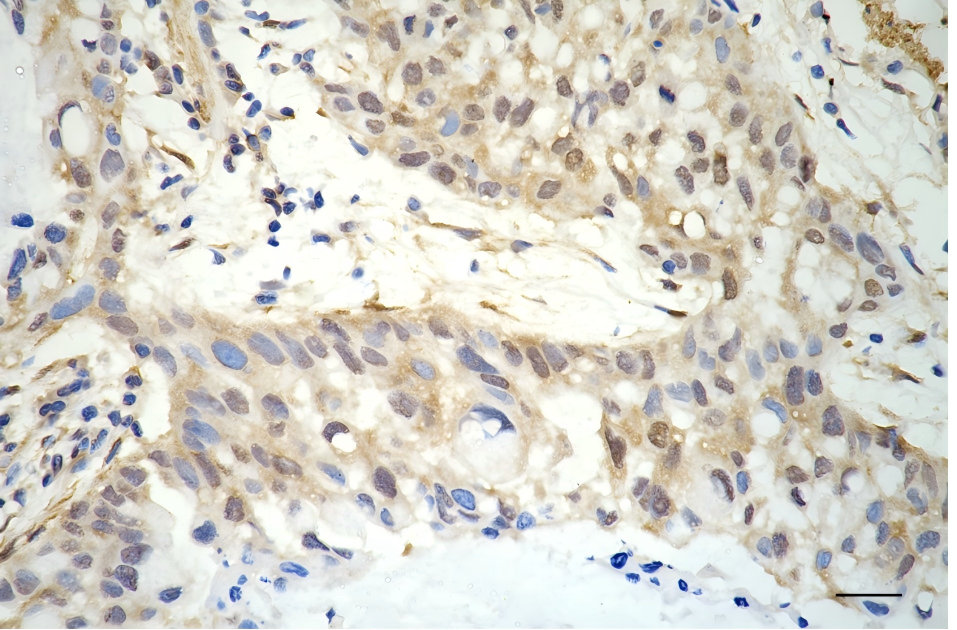

LPP Recombinant Monoclonal Antibody
-
中文名稱:LPP Recombinant Monoclonal Antibody
-
貨號(hào):CSB-RA992690A0HU
-
規(guī)格:¥1320
-
圖片:
-
Flow cytometric analysis of LPP expression in HT-1080 cells using LPP antibody. Green, isotype control; red, LPP.
-
Immunocytochemical staining of HT-1080 cells with LPP antibody. Nuclei were stained blue with DAPI; LPP was stained magenta with Alexa Fluor? 647. Images were taken using Leica stellaris 5. Protein abundance based on laser Intensity and smart gain: Medium. Scale bar, 20 μm.
-
Immunohistochemistry was performed on paraffin-embedded human lung adenocarcinoma using LPP antibody. Antigen retrieval was done in sodium citrate buffer (pH 6.0). DAB was used for detection, with hematoxylin counterstaining. Images were acquired using a Nikon Ci-L Plus microscope (40× objective). Scale bar: 25 μm.
-
Western blotting analysis using LPP antibody. Total cell lysates (20 μg) from various cell lines were loaded and separated by SDS-PAGE. The blot was incubated with LPP antibody and HRP-conjugated goat anti-rabbit secondary antibody respectively.
-
-
其他:
產(chǎn)品詳情
-
Uniprot No.:
-
基因名:LPP
-
別名:LIM Domain Containing Preferred Translocation Partner In Lipoma; LIM Domain-Containing Preferred Translocation Partner In Lipoma; Lipoma-Preferred Partner; Lipoma Preferred Partner Gene; Lipoma Preferred Partner; LIM Protein
-
反應(yīng)種屬:Human, Mouse, Rat
-
免疫原:Recombinant Human LPP protein
-
免疫原種屬:Homo sapiens (Human)
-
標(biāo)記方式:Non-conjugated
-
克隆類型:Monoclonal
-
抗體亞型:Rabbit IgG
-
純化方式:Affinity-chromatography
-
克隆號(hào):20E8
-
濃度:It differs from different batches. Please contact us to confirm it.
-
保存緩沖液:Rabbit IgG in PBS (pH 7.4) containing 50% glycerol, and 0.02% sodium azide.
-
產(chǎn)品提供形式:Liquid
-
應(yīng)用范圍:ELISA, WB, FC, ICC, IHC
-
推薦稀釋比:
Application Recommended Dilution WB 1:1000-1:5000 FC 1:200-1:2000 ICC 1:100-1:1000 IHC 1:100-1:200 -
Protocols:
-
儲(chǔ)存條件:Upon receipt, store at -20°C or -80°C. Avoid repeated freeze.
-
貨期:Basically, we can dispatch the products out in 1-3 working days after receiving your orders. Delivery time maybe differs from different purchasing way or location, please kindly consult your local distributors for specific delivery time.
-
用途:For Research Use Only. Not for use in diagnostic or therapeutic procedures.
相關(guān)產(chǎn)品
靶點(diǎn)詳情
-
功能:May play a structural role at sites of cell adhesion in maintaining cell shape and motility. In addition to these structural functions, it may also be implicated in signaling events and activation of gene transcription. May be involved in signal transduction from cell adhesion sites to the nucleus allowing successful integration of signals arising from soluble factors and cell-cell adhesion sites. Also suggested to serve as a scaffold protein upon which distinct protein complexes are assembled in the cytoplasm and in the nucleus.
-
基因功能參考文獻(xiàn):
- Data indicate a function for lipoma preferred partner (LPP) in the formation of invadopodia and a requirement for LPP in mediating the metastatic ability of breast cancer cells. PMID: 28436416
- This is the first report of epigenetic regulation of the intronic miR-28-5p expression by promoter DNA methylation of its host gene, LPP. PMID: 28775176
- meta-analysis provides robust estimates that polymorphisms in LPP and TAGAP genes are potential risk factors for celiac disease in Europeans and Americans PMID: 28208589
- this study shows the importance of PP2A complexes with the LIM domains of lipoma-preferred partner in cell adhesion and migration dynamics PMID: 26945059
- alteration of LPP expression markedly changes the collectiveness and metastatic potential of cancer cells PMID: 26028032
- Results suggest that rs4686484 is the functional variant in this locus, while LPP expression is decreased in CeD. PMID: 24334606
- 3q28 rs6444305 in LPP gene is associated with follicular lymphoma. PMID: 25279986
- interaction between LPP and alpha-actinin, an actin cross-linking protein, is necessary for TGFbeta-induced migration and invasion of ErbB2-expressing breast cancer cells. PMID: 23447672
- Three polymorphisms of LPP gene were selected and replicated in additional 1132 PCOS cases and 1142 controls. Our results suggest that LPP gene might be a novel candidate for PCOS PMID: 23056290
- The results suggest that genomic alterations and clearly deleterious sequence changes in the LPP gene are not a common cause of esophageal atresia/tracheoesophageal fistula or VACTERL association. PMID: 22639458
- LPP is a nucleocytoplasmatic shuttle protein linking focal adhesion dynamics to the transcriptional machinery. PMID: 19701494
- Gene expression levels of bcl-6, lpp and miR-28 are different in various diffuse large B cell lymphoma cell lines. PMID: 19236753
- haploinsufficiency of LPP may be a novel cause of conotruncal cardiac anomalies, particularly forms of tetralogy of Fallot PMID: 20949626
- LPP contains specific domains that enable its focal adhesion and nuclear targeting capacity PMID: 12441356
- Expression of the HMGA2-LPP fusion transcript in only 1 of 61 karyotypically normal pulmonary chondroid hamartomas. PMID: 12505264
- LPP and Scrib proteins localize in cell-cell contacts. This interaction links Scrib to a communication pathway between cell-cell contacts and the nucleus, and implicates LPP in Scrib-associated functions PMID: 15649318
- Translocation in chromosome 3 and 12 involves fusion of this protein with HMGA2 in pulmonary chondroid hamartoma. PMID: 16271958
- HMGA2-LPP fusion promotes chondrogenesis by upregulating cartilage-specific collagen gene expression through the N-terminal DNA binding domains. PMID: 16375854
- LPP appears to be a vascular smooth muscle (SMSC) differentiation marker that plays a role in regulating SMC migration. PMID: 16397143
- LPP can shuttle between the cytoplasm and the nucleus, suggesting they may transfer information directly from the cytoskeleton or focal adhesions to the transcription machinery. PMID: 16484626
- By manipulating LPP levels, we show that it acts to upregulate the transactivation capacity of PEA3. PMID: 16738319
- The function of LPP and palladin is context dependent, that they play a critical role in cytoskeletal remodeling, respond to signals induced by vascular injury as well as signals that induce smooth muscle cell hypertrophy, such as angiotension II. PMID: 17322171
- expression of LPP and palladin are modulated by a mix of mechanical cues, oxidative stress and substrate composition which translate into their up or down regulation in vessel wall injury and early atherogenesis. PMID: 19205907
顯示更多
收起更多
-
相關(guān)疾病:A chromosomal aberration involving LPP is associated with a subclass of benign mesenchymal tumors known as lipomas. Translocation t(3;12)(q27-q28;q13-q15) with HMGA2 is shown in lipomas.; DISEASE: Note=A chromosomal aberration involving LPP is associated with pulmonary chondroid hamartomas. Translocation t(3;12)(q27-q28;q14-q15) with HMGA2 is detected in pulmonary chondroid hamartomas.; DISEASE: Note=A chromosomal aberration involving LPP is associated with parosteal lipomas. Translocation t(3;12)(q28;q14) with HMGA2 is also shown in one parosteal lipoma.; DISEASE: Note=A chromosomal aberration involving LPP is associated with acute monoblastic leukemia. Translocation t(3;11)(q28;q23) with KMT2A/MLL1 is associated with acute monoblastic leukemia.
-
亞細(xì)胞定位:Nucleus. Cytoplasm. Cell junction. Cell membrane. Note=Found in the nucleus, in the cytoplasm and at cell adhesion sites. Shuttles between the cytoplasm and the nucleus. It has been found in sites of cell adhesion such as cell-to-cell contact and focal adhesion which are membrane attachment sites of cells to the extracellular matrix. Mainly nuclear when fused with HMGA2/HMGIC and KMT2A/MLL1.
-
蛋白家族:Zyxin/ajuba family
-
組織特異性:Expressed in a wide variety of tissues but no or very low expression in brain and peripheral leukocytes.
-
數(shù)據(jù)庫鏈接:
Most popular with customers
-
-
YWHAB Recombinant Monoclonal Antibody
Applications: ELISA, WB, IHC, IF, FC
Species Reactivity: Human, Mouse, Rat
-
Phospho-YAP1 (S127) Recombinant Monoclonal Antibody
Applications: ELISA, WB, IHC
Species Reactivity: Human
-
-
-
-
-